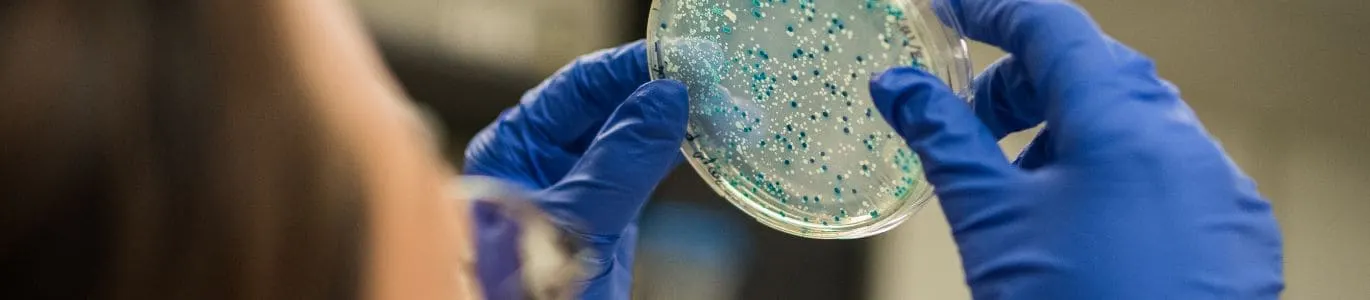

-
Telemedicina
-
Médicos a domicilio
-
Clínicas
-
Laboratorio Clinico
-
Estudios de gabinete
-
Seguros
-
Farmacias
-
Otros Servicios
Eliminar del Carrito
Este cambio eliminará todos los productos de su carrito. ¿De verdad quieres continuar?
Cultivo de secreciones
Filters >
